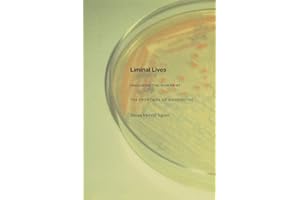
Liminal Lives: Imagining the Human at the Frontiers of Biomedicine

IMAGINING best sellers
Get a list of 58 IMAGINING best sellers on Amazon and Ebay . Period is past 7 days, last updated 2025-01-13.

|
#1 🔥 The Redstone Diary 2026 27.41 € on Amazon |
|

|
#2 🔥 Burma Sahib A fascinating 13.39 € on Amazon |
|

|
#3 🆕 The Engine Behind the 18.15 € on Amazon |
|

|
#4 AndrAs SzAntO Imagining 23.59 € on Amazon |
|

|
#5 AndrAs SzAntO Imagining 22 € on Amazon |
|

|
#6 Draw Fashion Now Techniques 26.83 € on Amazon |
|

|
#7 Imagining Australia 25.08 € on Amazon |
|

|
#8 Burma Sahib A fascinating 13.58 € on Amazon |
|

|
#9 Imagining Identity in 31.99 € on Amazon |
|

|
#10 British America 1500 1800 54.97 € on Amazon |
|

|
#11 A Dog's World Imagining 17.38 € on Amazon |
|

|
#12 Ezili's Mirrors Imagining 23.12 € on Amazon |
|

|
#13 The Hidden Pleasures 11.99 € on Amazon |
|

|
#14 Imagining the Divine 53.76 € on Amazon |
|

|
#15 🆕 Fantasy and Myth in the 30.79 € on Amazon |
|

|
#16 The Politics of Time 28.36 € on Amazon |
|

|
#17 Underworld Imagining 64.25 € on Amazon |
|

|
#18 Underworld Imagining 76.98 € on Amazon |
|
|
#19 Liminal Lives Imagining 22.84 € on Amazon |
|

|
#20 Resurrecting Tenochtitlan 58.18 € on Amazon |
Suggested best sellers
What's in Bestsellers.ai PRO ?
- 📊 Product Sales Estimates
- 💰 Total Sales Estimates
- 📜 Product Sales history
- 📅 52-Week Sales estimates
- 🔍 Advanced filtering
- ♻️ Second Hand and Refurbished market Data
Who uses Bestsellers.ai PRO ?
Trusted by e-merchants everywhere, Bestsellers.ai is their go-to for deciding what to sell next. Leading brands and retailers rely on us for crucial competitor insights and data-driven choices. 🚀
